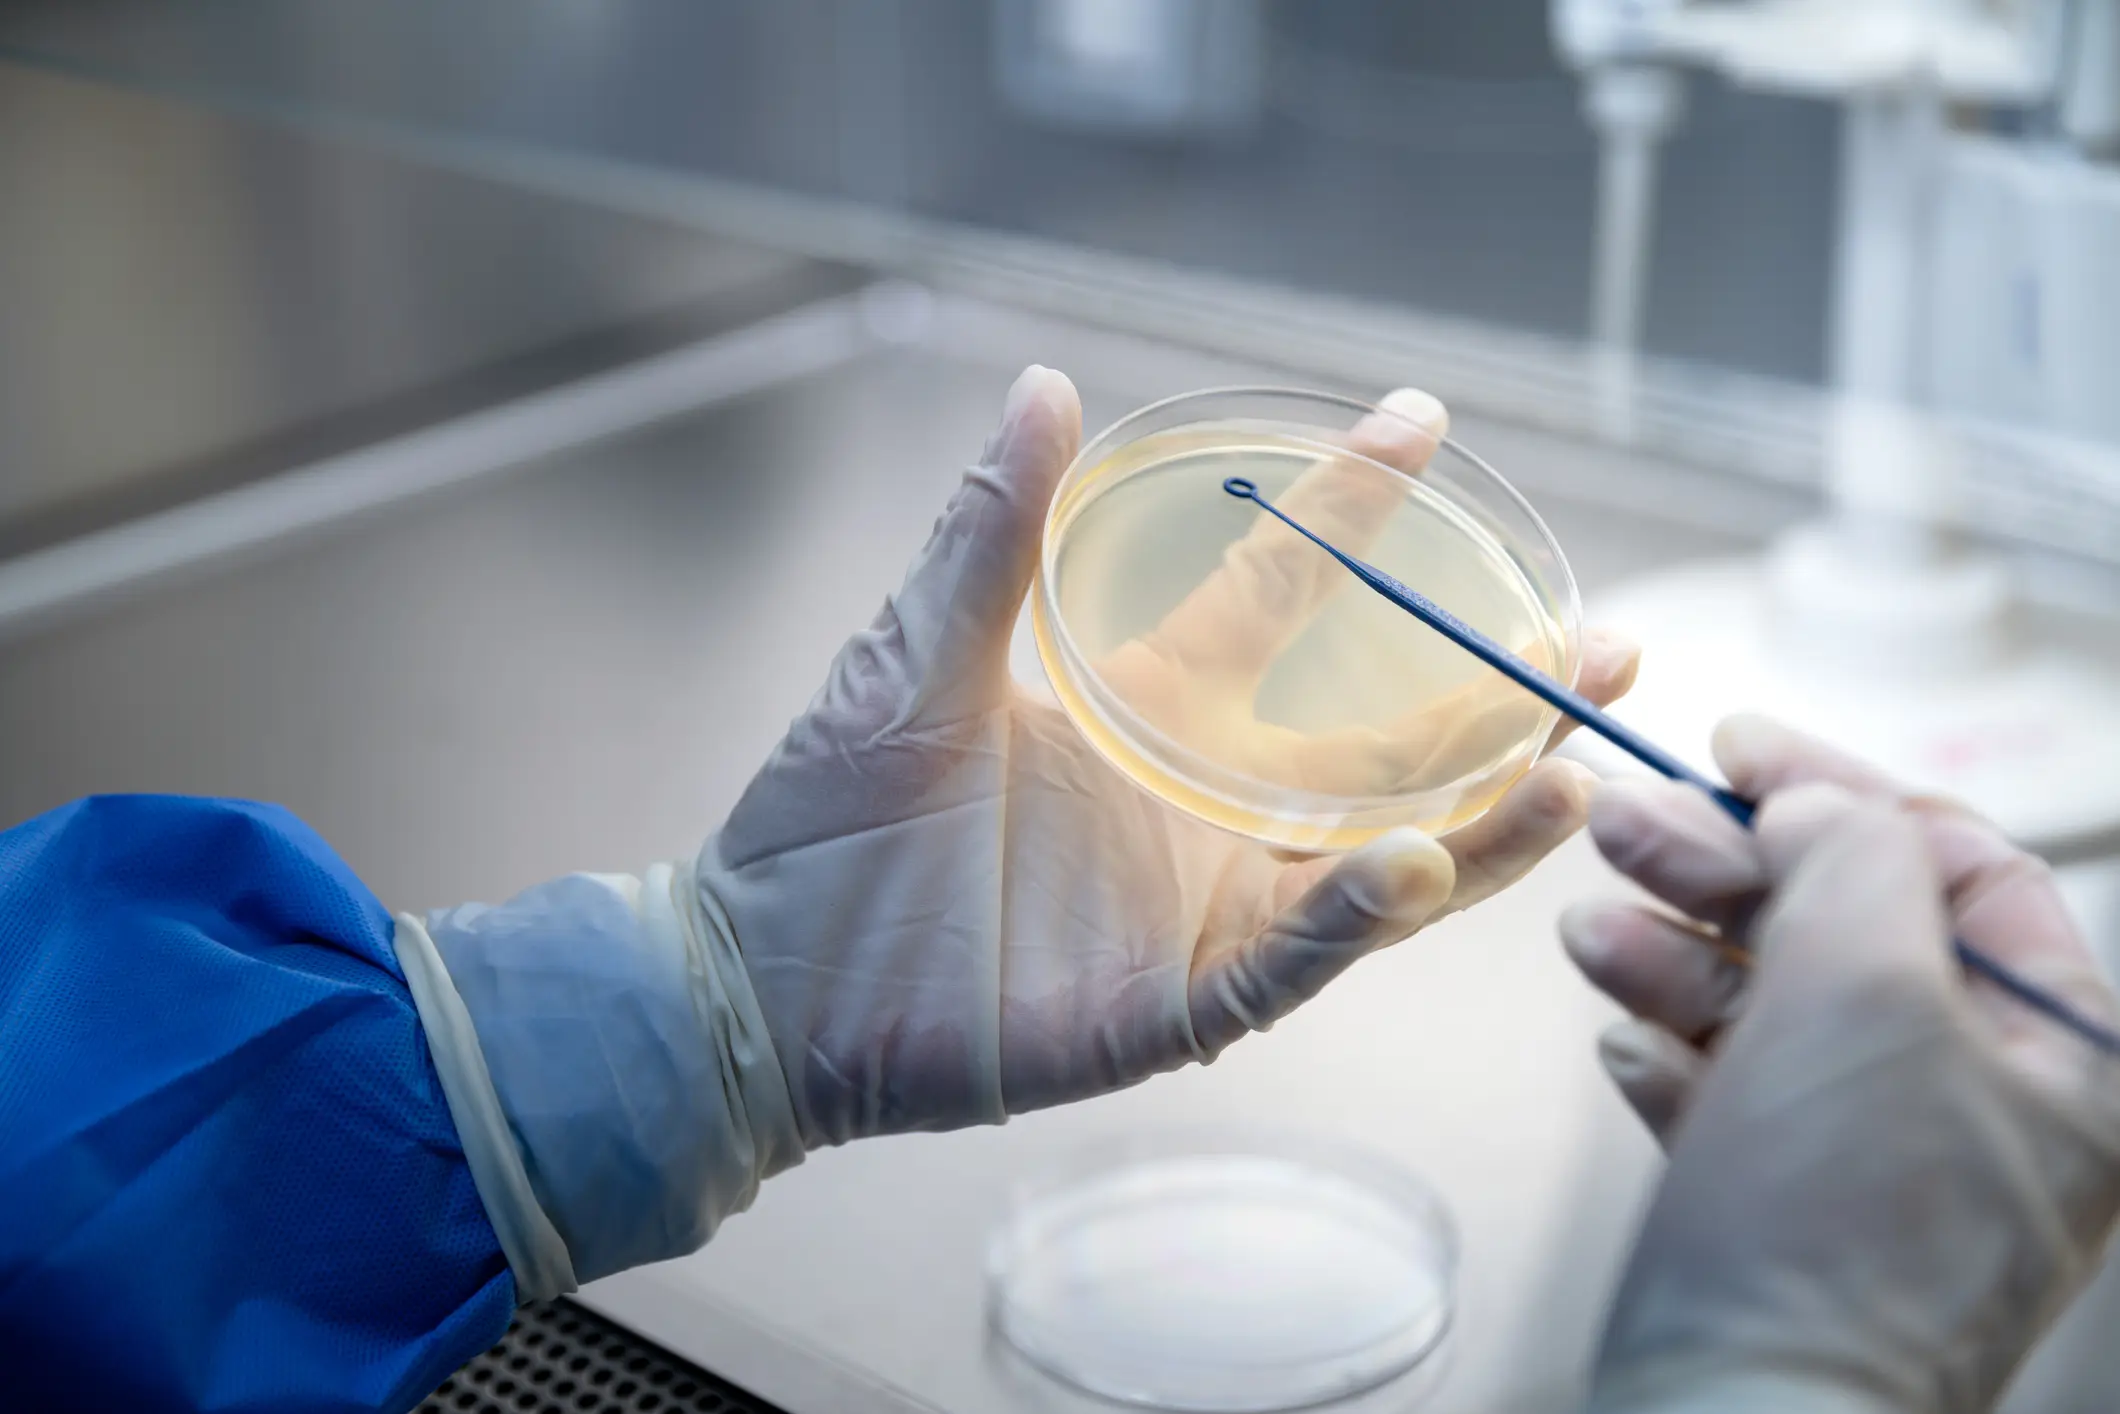
Bacterial constipation was researched and its origin found (Getty Stock Images)

If you’re struggling with your bowel movements, there could be a different reason that you've not heard of causing the nasty problem.
According to the NHS, one in seven adults in the UK are suffering from constipation at any one time.
The health service constitutes constipation as being bowel movements that are fewer than three each week, which can lead to symptoms like painful cramps in the tummy area, straining to poo, or not emptying your bowels fully, leading you to go back to the toilet to try again.
While a lot of the time, constipation is down to now getting enough fibre in your diet, which is essential for your overall gut health, it can also be microscopic reasons, like the type of bacteria that’s living in your gut.
Advert
You see, the gut is its own ecosystem, with good bacteria and bad bacteria, that needs to work in harmony to keep things running smoothly.
Sadly, it’s very easy for these things to go out of whack, which can be caused by a variety of things from medications, supplements, foods, drinks, and whatever else.
Once this happens, a person could be prone to getting things like irritable bowel syndrome, bloating, diarrhoea, and constipation.
But Japanese researchers have found it can also be down to two bacteria strains that could be the cause of your troubles, known as ‘bacteria constipation’.
The study was published in the journal Gut Microbes, which found that Akkermansia muciniphila and Bacteroides thetaiotaomicron can cause problems when there is too much of them together, leading them to team up to dry out the mucus in your anus, which helps to move along your stools.

The researchers collected faecal samples from 231 people suffering from Parkinson's Disease, as well as 54 patients with chronic idiopathic constipation (CIC), as these groups of people have been found to have more of those two types of bacteria in their guts.
They also tested 147 healthy people to find that functional constipation was more prevalent in those with less moisture in their stools, meaning they had more of the bacteria in their bodies.
According to the scientists, even when testing mice with both strains of bacteria led to them also suffering with constipation, leading them to understand that the overgrowth of the two wreaks havoc on the guy microbiome.
However, through bacterial suppression or ‘small molecules to block’ the bacteria, they observed more mucus, stool hydration and less constipation, which could point to a treatment plan for those suffering.